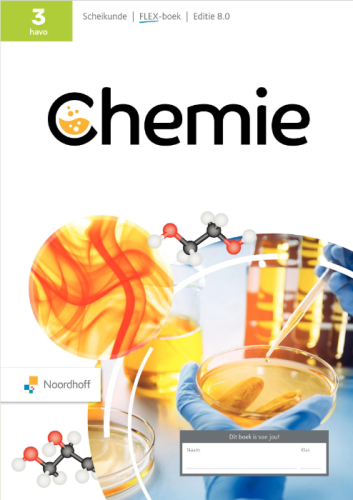

Chemie 8.0 ed/FLEX oefentoetsen & antwoorden
Hieronder vind je de toetsen die precies aansluiten op de hoofdstukken van dit lesboek. Controleer goed of je het juiste lesboek (editie/niveau) hebt geselecteerd.
Hoofdstuk 1 Mengsels
Hoofdstuk 1 Mengsels
Chemie 8.0 ed/FLEX
8e editie
Hoofdstuk 2 Reacties
Hoofdstuk 2 Reacties
Chemie 8.0 ed/FLEX
8e editie
Hoofdstuk 3 Moleculen en atomen
Hoofdstuk 3 Moleculen en atomen
Chemie 8.0 ed/FLEX
8e editie
Hoofdstuk 4 Brandstoffen
Hoofdstuk 4 Brandstoffen
Chemie 8.0 ed/FLEX
8e editie
Hoofdstuk 5 Duurzame chemie
Hoofdstuk 5 Duurzame chemie
Chemie 8.0 ed/FLEX
8e editie
Hoofdstuk 6 Gezondheid
Hoofdstuk 6 Gezondheid
Chemie 8.0 ed/FLEX
8e editie
Start ook met doelgericht leren
- Snel nog even wat toetsen oefenen? Kies dan onze meest flexibele optie.
- Je kunt maandelijks opzeggen.
- Toegang tot alle vakken bij ToetsMij.
Wat krijg je bij een abonnement?
- Toegang tot alle vakken
- 20 kwalitatieve oefentoetsen per maand
- Antwoorden, uitwerkingen en toelichtingen
- Geen stress voor het maken van toetsen
- Voordelig en flexibel. Ideaal als je maar een paar maanden toetsen hoeft te gebruiken.
- Betaal per kwartaal en bespaar hiermee 2 euro per maand.
- Toegang tot alle vakken bij ToetsMij.
Wat krijg je bij een abonnement?
- Toegang tot alle vakken
- 20 kwalitatieve oefentoetsen per maand
- Antwoorden, uitwerkingen en toelichtingen
- Geen stress voor het maken van toetsen
- Favoriete keuze van meer dan 70% van de gebruikers.
- Betaal slechts 90 euro per jaar en bespaar hiermee 65 euro.
- Geniet van een volledig jaar toegang tot alle vakken bij ToetsMij.
Wat krijg je bij een abonnement?
- Toegang tot alle vakken
- 20 kwalitatieve oefentoetsen per maand
- Antwoorden, uitwerkingen en toelichtingen
- Geen stress voor het maken van toetsen
Dit zeggen leerlingen en ouders
Cijfers omhoog
Onze zoon had in februari zeker 12 minpunten. Hij is gestart met oefenen via Toets mij en heeft een geweldige eindsprint getrokken en afgelopen week bijna het onmogelijke waargemaakt. Er zijn nog maar 2 minpunten over en nog niet alle toetsen zijn terug. Het heeft onze zoon enorm geholpen, omdat er breed getoetst wordt en de vraagstelling, zoals van hem begrepen, overeenkomt met de toets. Als je de oefentoetsen goed kunt maken, beheers je de stof echt goed!
Fijn dat leerlingen alvast een keer een toets kunnen oefenen die eruit ziet zoals op school.
Wij hebben sinds kort Toetsmij, omdat onze dochter het erg lastig heeft met Wiskunde. Op deze manier kan ze het hoofdstuk oefenen met een toets die qua vraagstelling overeenkomt met de toetsen op school. Nu kan ze dit dus eerst oefenen voordat ze de echte toets moet doen. Als docent Engels die werkt met Of Course en All Right kan ik bevestigen dat de toetsen grotendeels overeenkomen met de vraagwijze van de methode zelf. Dat is dus heel fijn voor leerlingen om te oefenen. We hadden heel even een dingetje met het nakijken, want de uitwerkingen werden niet goed weergegeven. Even een mailtje en binnen een dag reactie en ICT ging meteen aan de slag met het herstellen van de uitwerkingen. Super contact, goede dienstverlening! Aanrader!
Zéér tevreden!!
Lid geworden voor mijn zoon in leerjaar 1 van (toen 13) inmiddels 15. Hij zit nu in leerjaar 3 HAVO. Elk boek is makkelijk te vinden en alsmede mailt met een probleem omdat hij Duits krijgt uit een boek van leerjaar 2 word dit zelfs op zondag binnen een half uur opgelost en toegevoegd aan ons account! Zo’n toffe service zie je niet vaak meer! Dus wij zijn zéér tevreden. Sinds we het nu weer gebruiken (tijdje niet gebruikt) scoort hij weer voldoendes en zelf voor wiskunde een 8.8!
Zoek in meer dan 10.000 toetsen
Echte toetsvragen, precies aansluitend op jouw lesmethode en leerjaar. Voor klas 1 t/m 6 van vmbo-t t/m gymnasium.
